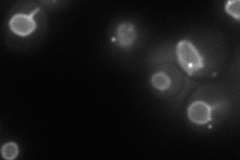
YML034W
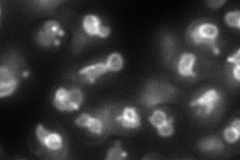
YML034W
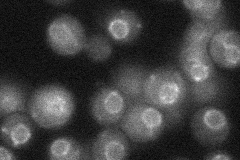
YML034W

View description
Inner nuclear membrane protein that functions in regulation of subtelomeric genes and is linked to TREX (transcription export) factors; SRC1 produces 2 splice variant proteins with different functions; possible role in chromatid segregation
Localization:
Intensity:
Fold change:
Significance:
-
C’ GFP library in SD

nuclear periphery21.56 -
N' NOP1pr-GFP in SD
punctate,nuclear periphery79.8525 -
N' TEF2pr-mCherry in SD
vacuole membrane87.6101 -
N' NATIVEpr-GFP in SD
punctate,nuclear periphery27.5085 -
N' TEF2pr-VC and Cyto-VN in SD

vacuole membrane35.6791 -
C’ GFP library in SD+DTT

nuclear periphery20.810.96No -
C’ GFP library in SD+H2O2

nuclear periphery19.490.9No -
C’ GFP library in Starvation Media

nuclear periphery18.970.87No -
C’ GFP library on the background of Pup2-DaMP

nuclear periphery -
C’ GFP library on the background of CCT mutant

nuclear periphery25.72411.19259No
